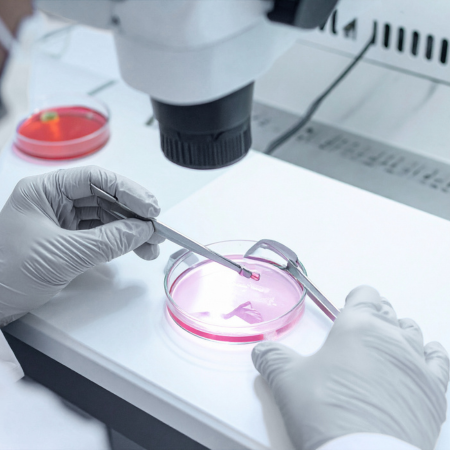

Bringing together a gentle approach and cutting-edge fertility treatments with Dr. Rudri A. Patel
Regular checkups are essential for early detection of potential issues.
Delivering comprehensive, compassionate care whenever it's needed.

Welcome to the official website of Dr. Rudri A. Patel, Fertility & IVF Specialist. We understand that infertility is not just a medical challenge but also an emotional journey. Our mission is to walk with you hand-in-hand, combining the latest technology in reproductive medicine with personalized care and empathy.

Dr. Rudri A. Patel is a seasoned Fertility & IVF Specialist, bringing a wealth of knowledge in reproductive medicine, gynaecology, obstetrics, and cutting-edge fertility techniques. With multiple fellowships under her belt in reproductive medicine, minimally invasive gynaecological surgery, and cosmetic gynaecology, she stands out as one of the few specialists in India with a broad expertise in various facets of women’s health. Her motto and guiding principle is straightforward: Every patient deserves hope. With a blend of warmth, empathy, and scientific accuracy, Dr. Rudri offers thorough care for couples facing infertility challenges.
Affiliations: Oasis Fertility, Motherhood, ESHRE, ASRM, ARGI, ISAR, IFS, FOGSI, ICOG
In addition to her clinical work, Dr. Rudri is actively involved in research and publications, concentrating on advanced fertility treatments, ovarian activation, genetics, and immunology in reproduction.
Why Us ?
Individualization - "One size does not fit for all."
We’re all about creating a warm and supportive space where science and compassion come together.

Every couple’s journey is one-of-a-kind, and so is our care plan tailored just for you.

We offer cutting-edge options like IVF, ICSI, genetic testing (PGT/NiPGT), egg freezing, ERA, and ovarian rejuvenation.
We believe in providing honest advice without pushing unnecessary procedures.
Counseling, nutrition, and lifestyle guidance are key parts of our approach.

Your privacy and dignity are always our top priority.


IVF specialist with internationally and nationally recognised advanced training

Fertility care offering ranges from basic treatments to advanced IVF, genetics, and Immunology

Patient-centred ethical approach with superior, care-driven success rates

use of advanced genetic testing, managing recurrent pregnancy loss, and ovarian rejuvenation
Committed to staying at the forefront of medical advancements,
We ensure that every patient receives the highest quality treatment tailored to their unique needs.

Our OPD services offer comprehensive consultations and treatments for a wide range of gynecological and obstetric conditions. Dr. Rudri ensures personalized care to address each patient's unique needs.

Regular antenatal check-ups are crucial for the health of both mother and baby. We provide thorough monitoring and management throughout your pregnancy to ensure a healthy and safe journey to motherhood.

Postnatal care is essential for the recovery and well-being of new mothers. We offer support and medical attention to help you navigate the postpartum period with confidence.

Whether you have a normal or caesarean delivery, Dr. Rudri's clinic is equipped to provide safe and comfortable birthing experiences. Our team is committed to supporting you through every step of the process.

We provide expert advice on various contraception options to help you make informed decisions about family planning and reproductive health.

Regular PAP tests are vital for early detection of cervical cancer. Our clinic offers routine screening to ensure your continued health and peace of mind.

Protect yourself with our comprehensive vaccination services. We offer a range of vaccines to safeguard your health during pregnancy and beyond.

Our state-of-the-art ultrasound (USG) facilities enable detailed imaging for accurate diagnosis and monitoring of various conditions during pregnancy and other gynecological concerns.

For treatments that do not require overnight stays, our day care admission facilities provide a comfortable and convenient option for patients to receive necessary treatments and return home the same day.

Our OPD services offer comprehensive gynecologic care, including routine checkups, diagnostics, and treatment for various women's health issues. Convenient and patient-focused, we ensure timely and effective medical attention.

Our PAP test services offer efficient and accurate screening for cervical cancer, helping to detect abnormalities early and prevent serious health complications. With a focus on patient comfort and confidentiality, we ensure a seamless experience and timely follow-up care.

Our vaccination facilities provide a convenient and comprehensive range of immunizations tailored to women's health needs, including HPV vaccines for cervical cancer prevention and other crucial vaccinations for reproductive health. With expert guidance and efficient administration, we prioritize your well-being and protection against preventable diseases.

Our USG facilities offer advanced ultrasound imaging services, providing detailed and accurate assessments for various gynecologic and obstetric conditions. With state-of-the-art equipment and experienced technicians, we ensure precise diagnosis and personalized care for our patients' reproductive health needs.

Intrauterine Insemination (IUI) is a simple and minimally invasive fertility treatment designed to increase the chances of conception. In this procedure, carefully prepared and concentrated sperm are directly placed into the uterus around the time of ovulation, helping the sperm reach the egg more efficiently.

Preimplantation Genetic Testing (PGT) is an advanced diagnostic technique used during IVF to evaluate the genetic health of embryos before they are transferred into the uterus. This helps in selecting embryos with the best potential for a healthy pregnancy.

IVF (In Vitro Fertilization) and ICSI (Intracytoplasmic Sperm Injection) are advanced fertility treatments designed to help couples achieve pregnancy when natural conception is challenging. In IVF, a woman’s eggs are carefully retrieved and combined with sperm in a controlled laboratory environment to allow fertilization.

At Oasis Fertility, we understand that fertility treatments can sometimes feel overwhelming. Our counselling services are designed to provide a safe, supportive space where you can openly discuss your concerns, expectations, and emotions. Whether you are just starting your journey or undergoing treatment, our experts guide you with clarity and compassion at every step.

At Oasis Fertility, we understand that fertility treatments can sometimes feel overwhelming. Our counselling services are designed to provide a safe, supportive space where you can openly discuss your concerns, expectations, and emotions. Whether you are just starting your journey or undergoing treatment, our experts guide you with clarity and compassion at every step.

At Oasis Fertility, rejuvenation approaches may include innovative methods such as platelet-rich plasma (PRP) therapy and other supportive treatments that aim to stimulate tissue repair and improve blood flow to the reproductive organs. These techniques can be beneficial for individuals with reduced ovarian reserve, thin endometrial lining, or previous unsuccessful treatment cycles.

Semen Analysis is a fundamental diagnostic test used to evaluate male fertility potential. It provides detailed insights into the health and quality of sperm, helping identify possible factors that may affect conception. This test examines key parameters such as sperm count, motility (movement), morphology (shape), and overall semen quality.

Follicular Monitoring is a key diagnostic procedure used to track the growth and development of ovarian follicles during a menstrual cycle. It helps determine the most accurate time for ovulation, increasing the chances of successful conception.

Ovarian Stimulation is an important step in many fertility treatments, designed to encourage the ovaries to produce multiple mature eggs within a single cycle. This increases the chances of successful fertilization and pregnancy.
How does conception happen?
For conception to occur, a woman’s egg needs to meet a man’s sperm, and the resulting embryo must successfully implant in the uterus. Several factors come into play here—hormones, ovulation, the health of the egg and sperm, and the uterine environment.
Fertility tends to decline with age, particularly after 30 for women. By the time they reach 40, both the quality and quantity of eggs drop significantly, making it more challenging to conceive.
Advanced age, irregular ovulation, PCOS, blocked fallopian tubes, endometriosis, diminished ovarian reserve, and uterine pathologies.
When it comes to male factors affecting fertility, we often see issues like low sperm count, poor motility, abnormal shapes, and high DNA fragmentation.
Sometimes, the causes can be a mix of these or even remain unexplained.
So, when should you consider reaching out for help?
If you’ve been trying to conceive for a year (if you’re under 35) or for six months (if you’re over 35), it’s time to talk to a professional. Other signs include having irregular or absent periods, a history of miscarriage, known conditions like PCOS or endometriosis, previous unsuccessful fertility treatments, or specific issues like azoospermia (which means no sperm) or oligoasthenoteratospermia.


Fertility Consultation & Tests: We offer hormone tests (like AMH and FSH etc ), semen analysis, ultrasounds, and genetic testing. Ovulation Induction: We use safe medications to help regulate ovulation. IUI (Intrauterine Insemination): This involves placing sperm directly into the uterus during ovulation.

IVF / ICSI (Test Tube Baby): This process involves fertilizing an egg outside the body and then transferring the embryo. ICSI: Here, we inject a single sperm into an egg, which is particularly useful for male infertility. Blastocyst Transfer: We transfer embryos that have developed for five days, which leads to higher success rates. FET (Frozen Embryo Transfer): This method allows us to freeze embryos safely and transfer them when conditions are just right.

PGT (Preimplantation Genetic Testing): This helps identify any chromosomal or genetic abnormalities. NiPGT: A safer, non-invasive way to test embryos. ERA (Endometrial Receptivity Analysis): This determines the optimal time for implantation.

We offer egg and sperm freezing for those looking to delay parenthood, as well as fertility preservation options before cancer treatments.

Ovarian Pricking & Rejuvenation for those with a poor ovarian reserve. We also provide advanced stimulation protocols, including PPOS and minimal stimulation IVF, among others.

We’ll take a deep dive into your history, have a heartfelt discussion, and conduct only necessary investigations.

Together, we’ll create a personalized treatment plan tailored just for you.

Whether it’s IUI, IVF/ICSI, PGT, or fertility preservation, we’ll provide what you need.

We’ll be right by your side, monitoring and caring for you during this vital step.

Our support continues until you’re holding your little one in your arms. We’re with you at every step of your journey, from that first consultation to the moment you welcome your baby.
Select your preferred date, time, and service in just a few clicks.

Dr. Rudri A. Patel Oasis Fertility, Indore

+91 9755045214

rudri28@gmail.com

Our heartiest Thanks to our gynaecologist
Dr. Rudri Agarwal Patel mam who has been there for us through out 9months of journey, her well experienced consultations, treatment &
giving proper time & attention towards your
regular check ups, reports & medications. She's always there for us on & off. Never minded our phone calls & messages for any query, doubt & required supports. Listened to us very carefully.
Once again Thanks a lot Mam.

Dr. Rudri is very compassionate and polite towards patient..she always takes call and gives proper response....she listens to each and every problem very carefully....she is highly recommended

My whole pregnancy journey was taken care by Rudri Ma'am, with all her expertise and jolly nature it becomes a great experience for us .

I recently had the pleasure of being treated by Dr. Rudri A.Patel, and I am extremely grateful for the care I received. Dr. Rudri is highly skilled, compassionate, and attentive. They took the time to listen to my concerns, thoroughly explain my options, and ensure I felt comfortable throughout my treatment. I highly recommend Dr. Rudri to anyone seeking exceptional gynecological care. Thank you, for making a positive difference in my health journey.

Hello....Rudri maam ko bahut thanks...mujhe night mein 2 baje pains aane lage and water break ho gaya...maine maam ko call kiya...maam ne usi time hospital aakar mujhe dekha..poori night vo mere sath hi rahi...and morning mein 6 Am par meri delivery ke baad hi vo gayi...i am very thankful to her for all efforts she made for my successful pregnancy and delivery...

Dr. Rudri a.Patel is fantastic! She’s knowledgeable, caring, and takes the time to address all concerns. The office is welcoming, and the staff is friendly and professional. Highly recommend for exceptional gynecological care!

After years of trying and facing disappointments, we were overjoyed to welcome a baby, all thanks to Dr. Rudri’s unwavering support and guidance.

Dr. Rudri took the time to explain everything to us and reignited our hope when we thought it was lost. Now, we’re proud parents!

Not really. IVF includes some minor injections and a quick procedure under short anaesthesia for egg collection. Most women handle it just fine.
That really depends on factors like your age, the reason for infertility, and the quality of the embryos. Many couples find success within 1 to 3 cycles.
Absolutely. Babies conceived through IVF are just as healthy as those conceived naturally, especially with the latest genetic screening options available.
The cost can vary based on the tests and procedures needed. We offer clear and straightforward packages.